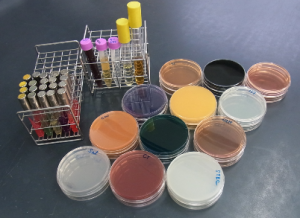

試験検査課・各支所
印刷用ページを表示する 掲載日:2021年11月4日更新
試験検査課・各支所の主な業務
食品安全対策事業に係る検査
食の安全・安心の確保を目的に県の食品監視計画に基づき、食品の細菌検査や食品添加物等の理化学検査を行っています。
細菌検査での試料調製 清涼飲料水検査の前処理

酸を加え、加熱して有機物を分解します。
感染症・食中毒の検査
腸管出血性大腸菌O157、赤痢等の感染症や食中毒が発生したときは、迅速な検査を行い原因究明や感染拡大防止に努めています。
検査で使用する培地の例
様々な種類の培地を使用して検査を行います。
HIV・梅毒・肝炎ウイルスのスクリーニング検査
保健所からの依頼によるスクリーニング検査を実施しています。
環境衛生関連施設等の水質検査
県立学校等のプール水や給水施設、公衆浴場の水質検査を実施しています。
学校プール水の過マンガン酸カリウム消費量
(滴定法)の検査

一般依頼検査(クリックすると検査案内のページが開きます。)
県民の皆様からのご依頼に基づき水質検査や検便検査等をお受けしています。窓口により受付日時が異なりますので、詳しくは検査案内のページをご確認下さい。
<検査項目の例>
- 検便検査(赤痢菌、チフス菌、パラチフスA菌、サルモネラ属菌、腸管出血性大腸菌O157)
- 食品検査(細菌検査:細菌数等、理化学検査:シアン化合物等)
- 井戸水等飲用水の水質検査
